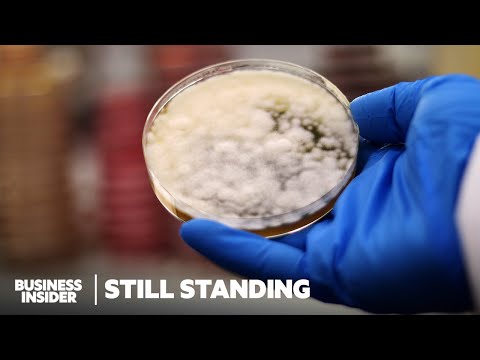
Less Than 1% of Japanese Sake Is Made This Traditional Way | Still Standing | Business Insider

Why Sake Brewing Is My New Obsession…

About
No channel description available.
Latest Posts
Video Description
This video is a beginners guide to brewing Sake at home covering the science of sake fermentation, koji making, brewing sake, bottling and finally a taste test to see how my sake performs against other popular brands. Sake Ratios Rice - 100% Koji - 25% (multiple total rice by .25 ) Water - 150% (multiply total rice amount by 1.5) Yeast - follow instructions on years package for amount used My Ratios in Video Rice - 10 Pounds Dried Rice (4.5 kilograms) Koji - 2.5 Pound Koji Water - 2 gallons (7.5 liters) Yeast - half my package of Sake Yeast which is good for a 5 gallons 00:00 - Intro 00:45 - What is Sake? 03:18 - Koji 06:45 - Sake Mash 12:27 - Bottling 13:26 - Taste test Learn to cook with confidence using my courses, cookbooks, and free recipes at https://lifebymikeg.com For products used in this video - https://www.amazon.com/shop/lifebymikeg Koji Cultures from Shared Cultures - https://www.shared-cultures.com/shop Full Video on Koji Making Here - https://www.youtube.com/watch?v=Llt80xkjp48&t=2s Music Credits: Epidemic Sound: https://www.epidemicsound.com Video Credits Creator, Host - Mike G Editor - Cooper Makohon Motion Graphics - Raphael Oliveira
You May Also Like
Essential Sake Brewing Gear
AI-recommended products based on this video

LEGO Botanicals Mini Orchid Building Set - Artificial, Fake Orchid for Home Decor, Adults Ages 18+ - Gift for Graduation- Indoor Plant Decorations for Table, Desk, Office - 10343

LEGO Botanicals Tiny Plants - Artificial, Fake Indoor Plant Building Set for Home, Kitchen, Desk Decoration, Adults Ages 18+ - Gift for Graduation - 10329

LEGO Icons Bonsai Tree Building Set - Artificial Bonsai Tree Plants for Home Decor, Adults Ages 18+ - Faux, Fake Plants for Table, Desk, Office - Birthday Gift for Men & Women - 10281